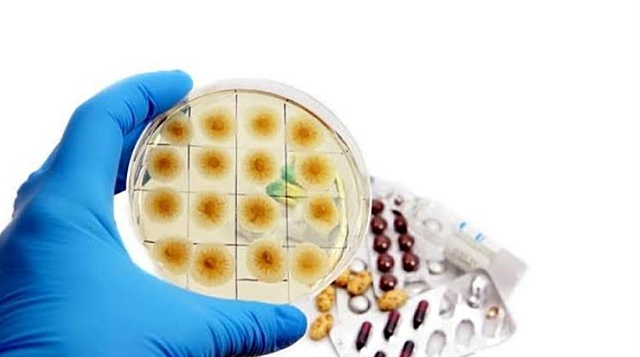
Penicilina

-
Movimiento cultural que surge en Europa en los sigos XV y XVII.
Sirvió de transición entre la edad media y la edad moderna. -
Desde la toma de Constantinopla en el siglo XV hasta la revoución Francesa en 1789. Concepción Salud-Enfermedad -Declive de la Inquisición.
-Comienzan a abandonarse las explicaciones religiosas a las enfermedades.
-Surgimiento de la mIcrobiología contribuye a la interpretación naturalista pero unicasua de la enfermedad.
-Se consolida el método científico organizandose alrededor de la enfermedad y la clínica.
-Medicina Indiviualista
-Surgimiento de las bases del concepto de hospital moderno. -
Leonaro Da Vinci plasma en su obra “El hombre del Vitruvio ” el estudio de las proporciones ideales del cuerpo humano, acompañado de notas anatómicas.
-
Leonardo Da Vinci hace descripciones detalladas de ateroesclerosis y cirrosis de hígado.
-
Andrés Vesalino descubrió la vena ácigos mayor y su esembocadura en la vena cava.
-
Andres Vesalino redacta “Humanis corporis fabrica libresptum” sobre la estructura del cuerpo humano.
dicha obra puede considerarse como el primer tratao moderno de anatomía. -
Ambrosio Paré hizo un gran descubrimiento al no cauterizar el muñon de los amputados para cohibir la hemorragia, sino hacerlo por meio de la ligadura de los vasos arteriales y venosos seleccionados.
-
Juan Valverde compuso “Historia de la composición del cuerpo humano ”
-
Juan Valverde compuso el pequeño libro de higiene “De animi et corporis sanitate tuenda libellus ”
-
Ambrosio Paré publico una monumenta obra de cirugía, “Dixliyres de la Chirurgue”.
La primera parte contenía anatomía y fisiología, la segunda describían muchas técnicas quirúrgicas, sieno una e las mas significantes el uso de pinzas y ligaduras. -
Paracelso publica su principal obra “Opera Omnia Medico ChemicoChirurgia” y escribe tratado de anatomía “Magna Chirurgia”
-
Hans y Zacharias Janseen crean el microscopio compuesto.
Está formado por dos tubos de latón, soportando una lente cada uno, que se deslizan dentro de otro tubo de latón que permite el enfoque.
Se considera el primer microscopio compuesto de la historia. -
-
Luis Mercado publica “Instituciones Chirurgicae” con el fin de un mayor aprenixaj de los cirujanos latinos.
-
Galileo Galilei presentó tambien su microscopio óptico utilizando un diseño basado en la combinación de una lente cóncava y una lente convexa.
-
William Harvey propone la teoría de la circulación y el papel de las venas y arterias (las venas llevan sangre al corazón y las arterias la conducen en el sentdo contrario)
-
Leeuwenhoek, es considerado el padre de la microbiología, por sus excepcionales observaciones del mundo microbiano a tráves de unos sencillos microscopios que el mismo construía.
Leeuwenhoek fue la primer persona que vio bacterias. -
Microscopio gigantes ideao por René Descartes. Descrito en su obra Dioptrique.
El ocular era un lente biconvexa y el objetivo, una planoconvexa.Estaba dotado de un espejo reflector. -
Se le considera el fundador de la anatomía microscópica y un de los biólogos más importates de todos los tiempos. Se le considera el fundador de la histología.
-
Robert hooke desarrolló el concepto de célula.
con un microscopio que el mismo fabricó, notó que el corcho y otros tejidos vegetales estan constituios por pequeñas cavidades separadas.
Llamó a estas cavidades “células” que significaba “Habitaciones pequeñas” -
Concepto innovador de la enfermedad, ya que las personas que habían contraído viruela y sobrevivido quedaban exentos, a lo cuál se le conoce como inmunidad.
-
-
Giovanni Bttista Morgagni imprimió en Pauda, Venecia su “De sedibus et causis morborum per anatomen indagatis” (“Sobre las localizaciones y las causas de las enfermedades investgadas desde el punto de vista anatómco”) que sentó las bases de la anatomía patológica modera como fundamento de la patoogía y la clínica.
-
Comienza con la Revolución Francesa en 1789 y se extiende hasta nuestros días. Concepción Salud-Enfermedad -Se comienza a tomar en cuenta al ser humano en su contexto social, economico y cultural para la concepcón de las prácticas de la salud.
-Movimiento de Salud Pública en pos de mejorar las condiciones de vivienda, higiene, y alimentación.
-Surge la epidemiología como método científico de análisis de epdemias.
-Vínculo estrecho entre la medicina y la biología. -
-
René Théophile, construyo un pequeño instrumento recto, realizado con hojas de papel arrollado. La calidad del sonido percibido era mejor y más nítida que la que se obtenía por medio de la auscultación directa.
-
Chevalier introduce los objetivos compuestos
-
Joseph Jackson inventa las lentes apocromáticas.
-
Crawford W. Long utiliza el dietiléter para proucir anestecia qurúrgica en una extiración de lesiones quísticas en la cabeza.
-
Louis Pasteur encuentra que las levaduras tienen relacio con el proeso de la fermentación.
-
Louis Pasteur inventa el proceso de pasteurización.
-
Se funda la Academia Nacional de Medicina
-
Louis Pasteur produjo la primer vacua desarrollaa en un laboratorio, la vacuna cotra el cólera aviar
-
El médico alemán, Robert Koch descubre el bacilo de la tuberculosis, además afirma qye la causa principal de las enfermedades son las bacterias.
-
Louis Pasteur desarrollo la vacuna antirrábica con virus vivos atenuados por pases sucesivos y fue aplicada por primera vez en 1885
-
Robert Koch descubre el bacilo de la cólera.
-
Descubrimiento de los rayos X por Wilhem Rontgen.
Aún hoy es la base de las técnicas que permiten explorar el interior del cuerpo e los pacientes. -
-
El primer transplante fue realizado en un animal, y el órgano transplantado fue un riñon.
Se llevo a cabo por Freerick Grant, Charles Best, James Collip y J.J.R -
Conforme la incipiente industrialización llegaba al territorio mexicano, José Vicente Villada expidió en el Estado de México un decreto que reconocía la incidencia de los accidentes de trabajo.
-
Se funda el Hospital General de México
-
Descubrmiento de la Insulina por Emerich Ullman
-
Se sintetiza la insulina y tiempo después es usada como tratamiento contra la diabetes.
-
Alexaner Fleming escubre la penicilina, mediante la observación y la experiencia al conocer y emplear las propiedades de los mohos.
-
Se hace otro gran avance quirúrgico, al desarrollarse la cirugía laparoscópica por Heinz Kals
-
Primer trasplante realizado a un ser humano, el órgano trasplantado fue un riñon.
-
Durante la presidencia de Abelardo L. Rodríguez se crea el Instituto Mexicano del Seguro Social.
-
Cración de la Secretaría de Salubridad y Asistencia, hoy mejor conocia como la Secretaría de Salud
-
-
Se crea la Organización Mundial de la Salud
-
Aparición del primer anticonceptivo oral realizado por Luis Ernesto Miramontes
-
Tras la invención y aplicación de la vacuna, los casos de Sarampión cayeron un 99%
-
Creación de la vacuna para la Rubeola
-
Ocurre el primer trasplante cardíaco en el ser humano, realizado por Rene Geronimo Favaloro
-
Creación de la vacuna contra la Hepatitis B
Want to make a timeline like this?
Use Timetoast to turn dates, events, milestones, and phases into a clear visual timeline you can build and share. Timetoast is a timeline maker for work, school, research, and stories.